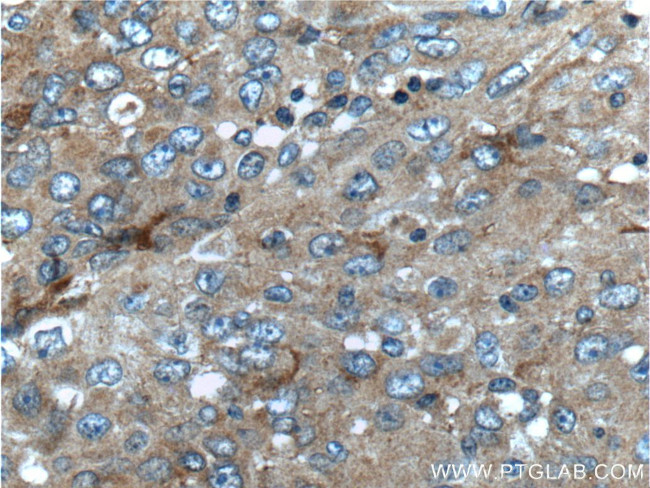
UCN Antibody in Immunohistochemistry (Paraffin) (IHC (P))

Search
Proteintech
UCN Polyclonal Antibody
{{$productOrderCtrl.translations['antibody.pdp.commerceCard.promotion.promotions']}}
{{$productOrderCtrl.translations['antibody.pdp.commerceCard.promotion.viewpromo']}}
{{$productOrderCtrl.translations['antibody.pdp.commerceCard.promotion.promocode']}}: {{promo.promoCode}} {{promo.promoTitle}} {{promo.promoDescription}}. {{$productOrderCtrl.translations['antibody.pdp.commerceCard.promotion.learnmore']}}
产品信息
21951-1-AP
种属反应
宿主/亚型
分类
类型
抗原
偶联物
形式
浓度
规格
纯化类型
保存液
内含物
保存条件
运输条件
产品详细信息
Immunogen sequence: MRQAGRAAL LAALLLLVQL CPGSSQRSPE AAGVQDPSLR WSPGARNQGG GARALLLLLA ERFPRRAGPG RLGLGTAGER PRRDNPSLSI DLTFHLLRTL LELARTQSQR ERAEQNRIIF DSVGK (1-124 aa encoded by BC104470)
靶标信息
Urocortin (UCN), a 40 amino acids neuropeptide widely distributed in the central nervous system (CNS), belongs to a family of structurally related peptides including corticotrophin releasing factor (CRF), sauvagine and urotensin I. Urocortin is derived from a larger precursor protein (pro-urocortin, also named corticotensin). Urocortin has biological actions similar to CRF such as stress-related endocrine, autonomic and behavioral responses in mammalian species. It is a potent stimulator of adrenocorticotropic hormone (ACTH) secretion by corticotroph cells from the anterior pituitary in vitro and in vivo.
仅用于科研。不用于诊断过程。未经明确授权不得转售。
篇参考文献 (0)
生物信息学
蛋白别名: prepro-urocortin; UCN; Urocortin; urocortin, preproprotein
基因别名: UCN; UCN1; UI; UROC
UniProt ID: (Human) P55089
Entrez Gene ID: (Human) 7349